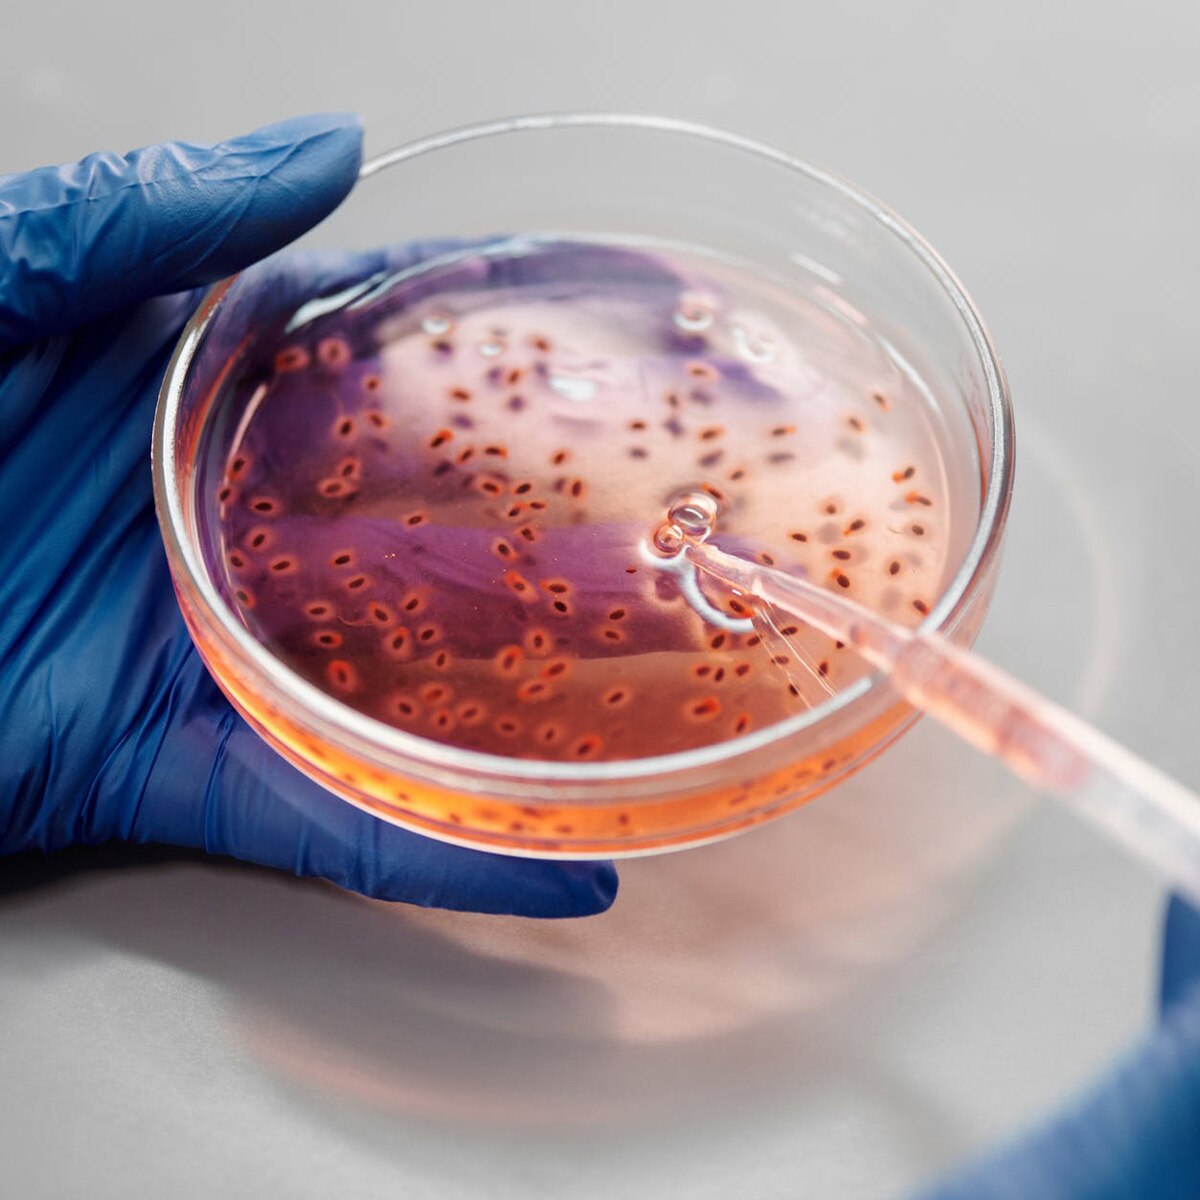
प्रतीकात्मक तस्वीर

महिला ने पति-बेटी से सालों तक छिपाया ये सीक्रेट, एक 'गिफ्ट' से हुआ खुलासा
अमेरिका में एक शख्स क्रिसमस के मौके पर अपनी गर्लफ्रेंड को एक खास तरह का गिफ्ट देना चाहता था लेकिन उसे बिल्कुल अंदाजा नहीं था कि उसका ये गिफ्ट उसकी गर्लफ्रेंड के परिवार के 30 साल पुराने राज को उजागर कर देगा. इस शख्स ने रेडिट रिलेशनशिप एडवाइज फोरम पर ये त्रासदी भरा किस्सा शेयर किया है.
इस शख्स ने पोस्ट में कहा कि उसने क्रिसमस के मौके पर एक डीएनए टेस्टिंग किट अपने पार्टनर के लिए खरीदी थी लेकिन इस किट ने इस शख्स की गर्लफ्रेंड की जिंदगी में भूचाल ला दिया. दरअसल जब इस किट के टेस्ट उजागर हुए तो इस लड़की ने देखा कि उसके परिवार के सदस्यों में एक लड़की का नाम भी शामिल था जो उसकी सौतेली बहन थी.
जब इस महिला ने अपनी मां से इस बारे में फोन पर पूछा तो उन्होंने सौतेली बहन की बात को लेकर साफ इंकार कर दिया लेकिन जब इस लड़की ने अपनी मां से जॉन स्मिथ नाम के शख्स के बारे में पूछा तो वह हैरान रह गई. दरअसल डीएनए टेस्ट में सामने आया था कि इस महिला की सौतेली बहन के पिता का नाम जॉन स्मिथ था.
इसके बाद इस महिला की मां ने फोन पर पूरा माजरा समझाया. दरअसल 30 साल इस महिला की मां ने कुछ दिनों के लिए ब्रेक लिया था और वह अपने एक्स बॉयफ्रेंड जॉन स्मिथ से मिलने चली गई थीं. इसके कुछ हफ्तों बाद उन्हें एहसास हुआ कि वे प्रेग्नेंट हैं और उन्हें पता था कि इस बच्चे के पिता जॉन हैं. ऐसे में उन्होंने 30 सालों तक अपनी सौतेली बेटी की बात को अपने परिवार से सीक्रेट रखा था.
अपनी मां की ये बात सुनकर महिला हैरान रह गई. वहीं ये शख्स उस वक्त को कोस रहा था जब उसने अपनी गर्लफ्रेंड को डीएनए किट देने का फैसला किया था. रेडिट पर ये सोशल मीडिया पोस्ट काफी वायरल हो रहा है और कई लोग ऐसे हैं जो इस मामले में कमेंट कर रहे थे कि सच हमेशा कड़वा ही होता और इस व्यक्ति को इस मामले में अपने आपको दोष देने की जरूरत नहीं है.